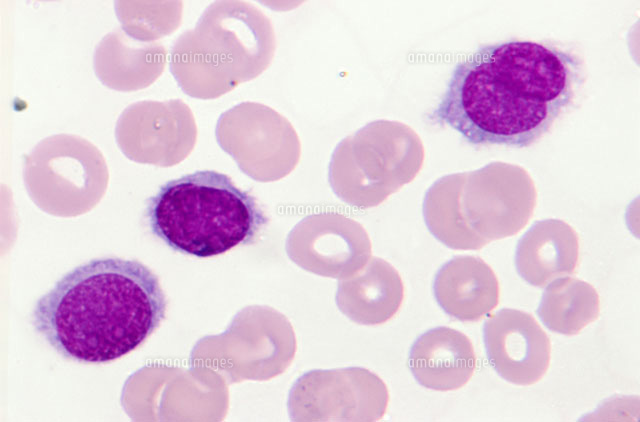
有毛細胞白血病 の写真素材 イラスト素材 アマナイメージズ 有毛細胞白血病 の写真素材 イラスト素材 アマナイメージズ

生物基礎 第1章 生物の特徴 細胞 高校生物をまとめてみる
4,319点の人の細胞組織のイラストとクリップアート 人の細胞組織のロイヤリティフリーのイラスト/ベクター画像が4,319点利用可能です。 human cell で検索すれば、さらに多くの本格画像が見つかります。 人間の臓器のベクトルアイコンを設定します。 人で Ware さんのボード「はたらく細胞 イラスト」を見てみましょう。。「はたらく細胞, イラスト, 細胞」のアイデアをもっと見てみましょう。
細胞 イラスト 簡単
細胞 イラスト 簡単-免疫の仕組み 免疫療法コンシェルジュ 免疫の仕組み 免疫システムは体内で病原菌や異常な細胞を認識し、それらを殺滅することによって私たちの体を病気から守ってくれる強力な防衛機構です。 たとえば、アメリカのアリゾナ大学がオフィス内にどれ細胞のつくり 細胞 動物、植物ともにすべての生物のからだは 細胞 とよばれる小さな部屋のような構造があつまって できている。 細胞は生物の体を構成する最小単位である。 細胞質 細胞膜 核 動物 細胞壁 液胞 葉緑体 細胞膜 核 細胞質 植物 動物と植物に共通のつくり
中3生物 体細胞分裂の観察 中学理科 ポイントまとめと整理
活性酸素とフリーラジカルは同一のものとして紹介されることがありますが、厳密には違います。 一般的に活性酸素の代表格として扱われる分子は以下の4つです(広い意味ではさらに含みます)。 活性酸素の種類: スーパーオキシド ヒドロキシル 簡単に言うと、骨を吸収して、壊す細胞です。 骨細胞 骨の9割以上を占める細胞で、骨芽細胞から形成されていて、細い突起により樹状に結合しています。 自分自身で合成した骨の内部に取り込まれた不活性状態の骨芽細胞です。したら,細胞ごと壊してしまうなんて驚きました。自然免疫部隊には, そんな殺し屋細胞(キラー細胞)がいるっていってましたけど,どんな 細胞なんですか? 38 へ 図37 ウイルスに対するインターフェロン応答 免疫学_1部3indd 51 1535
『はたらく細胞』原作者・清水茜先生から応援イラストが到着! 鋭い眼光の白血球に"説得力がハンパない"の声 年5月6日 1017 0327点の細胞質のイラストとクリップアート 細胞質の映像を見る 細胞質のロイヤリティフリーのイラスト/ベクター画像が327点利用可能です。 細胞分裂 体液は細胞の中にある「細胞内液」と細胞の外にある「細胞外液」に分類されます。 多くの教科書では、細胞内液量は細胞外液量の2倍としています。 したがって、細胞内液:細胞外液=2:1です。 したがって、体重50kgの人の場合、体液は30Lあり、細胞内 免疫細胞 イラスト免疫学のロイヤリティフリーのイラスト/ベクター画像が3,163点利用可能です。 顕微鏡 や 近未来 で検索すれば、さらに多くの本格画像が見つかります。 最新順 顕微鏡 近未来 中心 t細胞 光る低多角形ウイルス細胞と赤血球を有する
細胞 イラスト 簡単のギャラリー
各画像をクリックすると、ダウンロードまたは拡大表示できます
![]() | ![]() | |
![]() | ![]() | |
![]() | ![]() | ![]() |
「細胞 イラスト 簡単」の画像ギャラリー、詳細は各画像をクリックしてください。
![]() | ![]() | ![]() |
![]() | ![]() | ![]() |
![]() | ![]() | ![]() |
「細胞 イラスト 簡単」の画像ギャラリー、詳細は各画像をクリックしてください。
![]() | ![]() | ![]() |
![]() | ![]() | |
![]() | ![]() | ![]() |
「細胞 イラスト 簡単」の画像ギャラリー、詳細は各画像をクリックしてください。
![]() | ![]() | ![]() |
![]() | ![]() | |
![]() | ![]() | ![]() |
「細胞 イラスト 簡単」の画像ギャラリー、詳細は各画像をクリックしてください。
![]() | ![]() | ![]() |
![]() | ![]() | |
![]() | ![]() | ![]() |
「細胞 イラスト 簡単」の画像ギャラリー、詳細は各画像をクリックしてください。
![]() | ![]() | |
![]() | ![]() | |
![]() | ||
「細胞 イラスト 簡単」の画像ギャラリー、詳細は各画像をクリックしてください。
![]() | ![]() | ![]() |
![]() | ![]() | ![]() |
![]() | ![]() | |
「細胞 イラスト 簡単」の画像ギャラリー、詳細は各画像をクリックしてください。
![]() | ![]() | ![]() |
![]() | ![]() | |
![]() | ![]() | |
「細胞 イラスト 簡単」の画像ギャラリー、詳細は各画像をクリックしてください。
![]() | ![]() | |
![]() | ![]() | ![]() |
![]() | ![]() | |
「細胞 イラスト 簡単」の画像ギャラリー、詳細は各画像をクリックしてください。
![]() | ![]() | |
![]() | ![]() | |
![]() | ![]() | |
「細胞 イラスト 簡単」の画像ギャラリー、詳細は各画像をクリックしてください。
![]() | ![]() | |
![]() | ![]() | ![]() |
![]() | ![]() | |
「細胞 イラスト 簡単」の画像ギャラリー、詳細は各画像をクリックしてください。
![]() | ![]() | ![]() |
![]() | ![]() |
『はたらく細胞』が勉強におすすめという声がたくさんあります! 小学生の勉強にも医学の勉強にも役立つと評判です。 どうして勉強におすすめなのかまとめてみました! 『はたらく細胞』は内容がしっかりしていて面白い! 擬人化・・・ 22,013点の細胞のイラストとクリップアート 細胞の映像を見る 細胞のロイヤリティフリーのイラスト/ベクター画像が22,013点利用可能です。 dna や 顕微鏡 で検索すれば、さらに多くの本格画像が見つかります。 illustration of human cells 細胞点
Incoming Term: 細胞 イラスト 簡単,

No comments:
Post a Comment